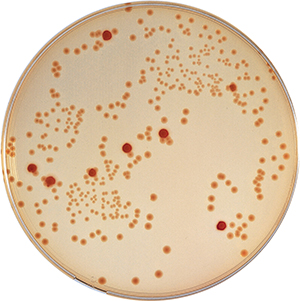

Escherichia coli O157 "koli basili" tabir edilen E. coli bakterisinin en zararlı tipi sayılır. Bir gıda zehirlenmesi etmeni olup hemorajik kolit denen hastalığa neden olur. Enfeksiyon bağırsak krampları ile başlar, bunu önce sulu ishal, sonra da çoğu zaman kanlı ishal izler. Bazen küçük çocuklarda hemolitik üremik sendrom olarak adlandırılan böbrek yetmezliği meydan gelir. Genelde bu bakteriyi içeren kıyma/etin az pişirilerek yenmesi sonucu zehirlenme meydana gelir. Bakteri ayrıca kişiden kişiye dokunma yoluyla, pastörize edilmemiş süt içmekle, bakterinin karıştığı suyla sulanmış sebze veya meyvelerin yenmesiyle, böyle suda yüzmek veya onu içmek yoluyla da bulaşır. Gıda ürünlerinde düzenli olarak Escherichia coli 0157 Analizi yaptırılmasında fayda vardır.
Uygun koşullarda gıda kontrol laboratuvarımıza ulaştırılan numune, gıda mikrobiyolojisi laboratuvarında steril koşullarda kalibrasyonlu alet ve ekipmanlarımızla 3 günlük bakteriyolojik ekim yapılarak tespit edilme/tespit edilmeme sonuçları Türk Gıda Kodeksi Mikrobiyolojik Kriterler Yönetmeliğindeki referanslara göre değerlendirilirek raporlama süreci tamamlanır.
Escherichia coli O157 Analizi
3-4 iş günü
500 g / 500 ml
Mikrobiyolojik
Bu analiz TURKAK tarafından TS EN ISO/IEC 17025 standardına göre akredite edilmiştir. TS EN ISO 16654 standardına göre çalışılmaktadır.
-
0,00TL
- KDV Dahildir



-228x228.jpg)




